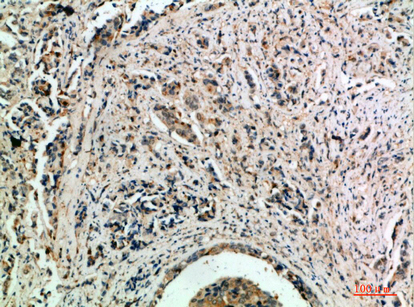

-
分类: 科研抗体货号: P23231别名: MYH1; Myosin-1; Myosin heavy chain 1; Myosin heavy chain 2x; MyHC-2x; Myosin heavy chain IIx/d; MyHC-IIx/d; Myosin heavy chain; skeletal muscle; adult 1; MYH2; MYHSA2; Myosin-2; Myosin heavy chain 2Myosin heavy chain 2; Myosin heavy chain 2a; MyHC-2a; Myo应用: WB,IHC反应种属: Human,Mouse,Rat
-
分类: 科研抗体货号: P23232别名: similar to transducin-like enhancer of split 1/2/3/4应用: WB反应种属: Human,Mouse,Rat
-
分类: 科研抗体货号: P23245别名: ZKSCAN4; ZNF307; ZNF427; Zinc finger protein with KRAB and SCAN domains 4; P373c6.1; Zinc finger protein 307; Zinc finger protein 427应用: WB,IHC反应种属: Human
-
分类: 科研抗体货号: P23230别名: CXCR6; BONZO; STRL33; TYMSTR; C-X-C chemokine receptor type 6; CXC-R6; CXCR-6; CDw186; G-protein coupled receptor STRL33; G-protein coupled receptor bonzo; CD186应用: WB,IHC反应种属: Human
-
分类: 科研抗体货号: P23244别名: SIGLEC7; AIRM1; Sialic acid-binding Ig-like lectin 7; Siglec-7; Adhesion inhibitory receptor molecule 1; AIRM-1; CDw328; D-siglec; QA79 membrane protein; p75; CD328应用: WB,IHC反应种属: Human
-
分类: 科研抗体货号: P23229别名: INHBE; Inhibin beta E chain; Activin beta-E chain应用: WB,IHC反应种属: Human,Mouse,Rat
-
分类: 科研抗体货号: P23243别名: CD1E; T-cell surface glycoprotein CD1e; membrane-associated; hCD1e; R2G1; CD1e应用: WB,IHC反应种属: Human
-
分类: 科研抗体货号: P23228别名: LAYN; Layilin应用: WB,IHC反应种属: Human,Mouse,Rat
-
分类: 科研抗体货号: P23242别名: APLN; APEL; Apelin; APJ endogenous ligand应用: IHC反应种属: Human,Mouse,Rat
-
分类: 科研抗体货号: P23227别名: BMP8A; Bone morphogenetic protein 8A; BMP-8A应用: WB,IHC反应种属: Human,Mouse,Rat

鄂公网安备42018502007531号
鄂公网安备42018502007531号

